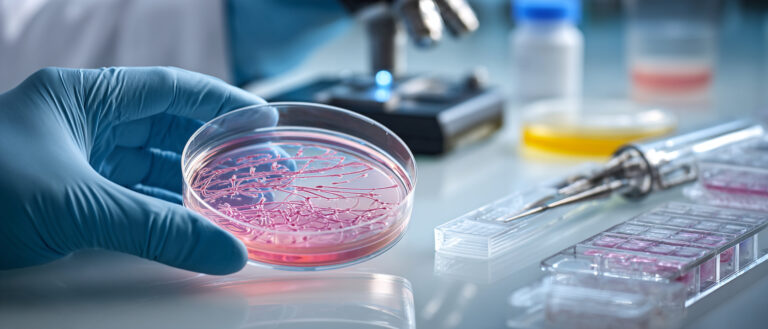

Authors: Toyoshima M, Kyo S, Horie A, Kobayashi E, Terai Y, Yamashita T, Fujii T, Asada H, Terao Y, Sekiyama K, Sone K, Mandai M, Committee for Gynecologic Oncology Surgery, Japan Society of Gynecologic and Obstetric Endoscopy and Minimally Invasive Therapy (JSGOE).
DOI: 10.1111/jog.70138
Abstract Summary
Japanese survey of 424 gynecologic oncologists reveals declining lymph node dissection in endometrial cancer is primarily driven by evolving clinical guidelines rather than work-style reforms. While minimally invasive surgery is widely adopted, criteria for omitting lymphadenectomy vary significantly between institutions. Molecular classification adoption is growing, but sentinel lymph node biopsy remains underutilized.
Why Brain? ๐ง
Survey reveals Japanese clinical guidelines, not work-hour reforms, drive declining lymph node dissection rates in minimally invasive endometrial cancer surgery, with molecular testing adoption rising.
Study Limitations:
Cross-sectional survey design
Single country study limited to Japan
Response rate of 67.8% with potential non-response bias
License: cc by.
The image is AI-generated for illustrative purposes only. Courtesy of Midjourney.